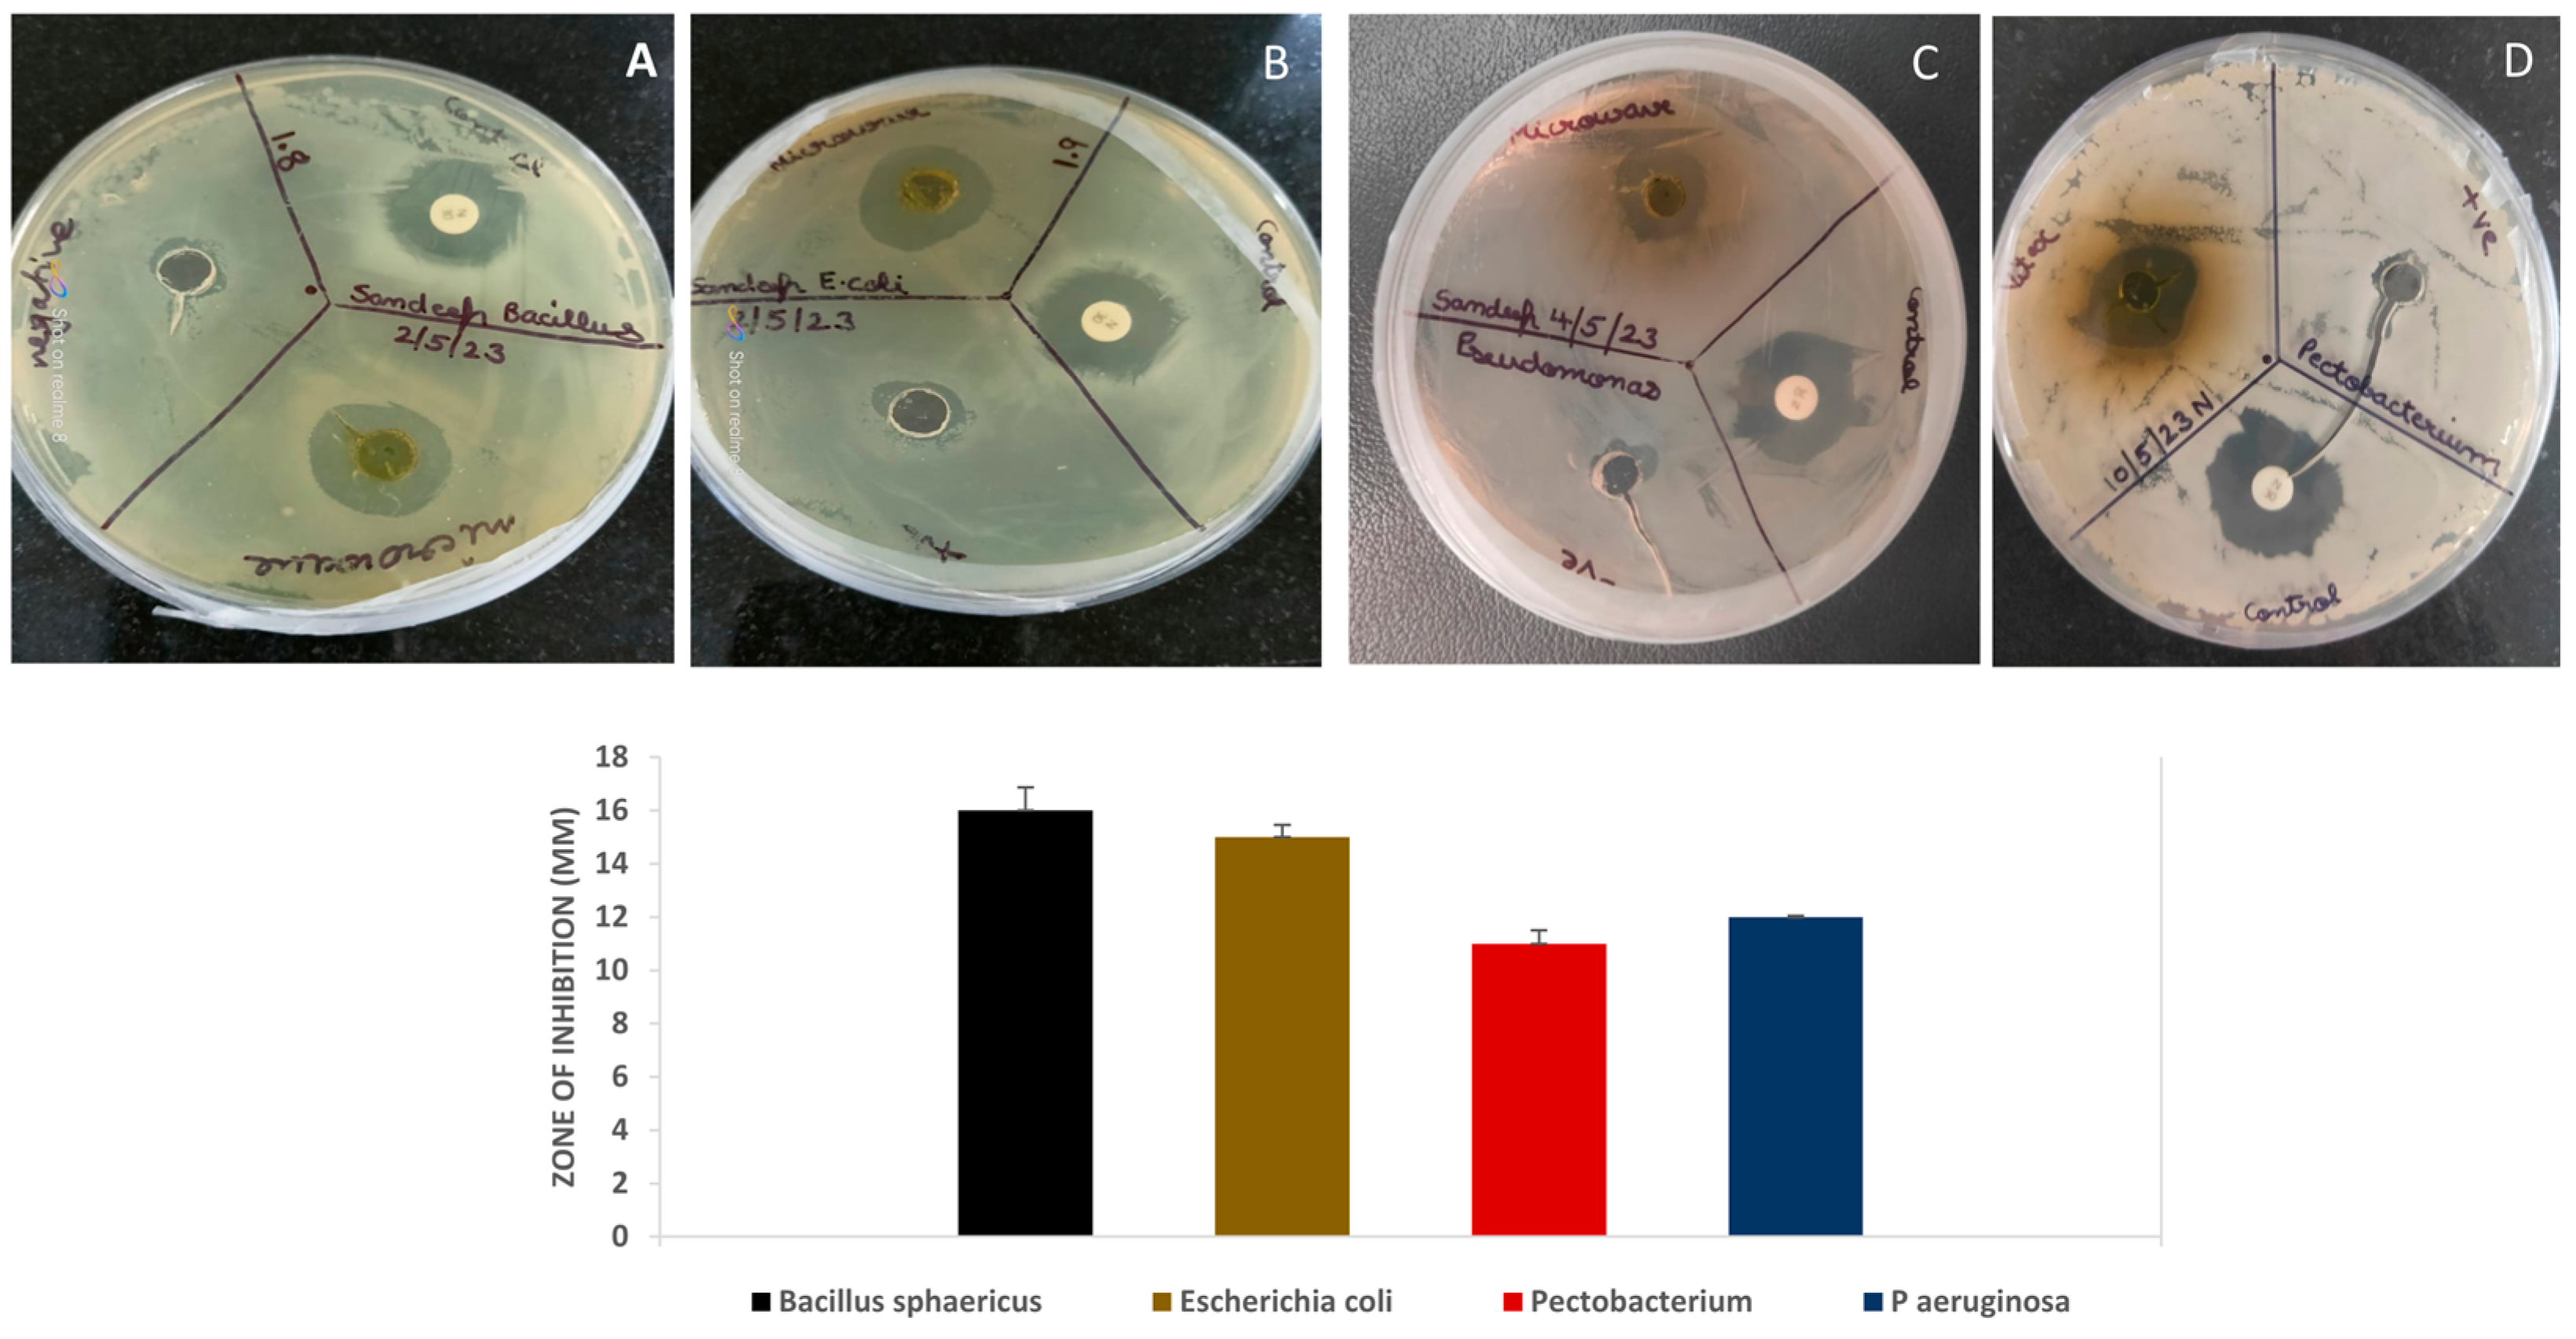
Colloids 09 00055 g005

Phytochemical-Assisted Fabrication of Biogenic Silver Nanoparticles from Vitex negundo: Structural Features, Antibacterial Activity, and Cytotoxicity Evaluation
Abstract
1. Introduction
2. Material and Methods
2.1. Plant Material
2.2. Detection of Phytoconstituents
2.3. Bioactive Constituent Examination
2.3.1. Qualitative Screening
2.3.2. Quantitative Screening
2.3.3. GC-MS Chromatography
2.4. Optimization of Bio Fabrication of VN-AgNPs
2.4.1. Temperature
2.4.2. Incubation Time
2.4.3. Effect of pH
2.4.4. Leaf Extract Volume
2.4.5. AgNO3 Concentration
2.5. Characterization of VN-AgNPs
2.5.1. UV-VIS Spectroscopy
2.5.2. FTIR (Fourier Transform Infrared) Analysis
2.5.3. X-Ray Diffraction Analysis (XRD)
2.5.4. SEM-EDX
2.5.5. Dynamic Light Scattering (DLS) and Zeta Potential
2.6. Antibacterial and Hemolytic Activity
2.6.1. Disk Diffusion Method
2.6.2. Hemolytic Activity
2.7. Statistical Analysis
3. Results
3.1. Phytochemical Extraction
3.2. Phytochemical Screening
3.2.1. Qualitative
3.2.2. Quantitative
3.2.3. GC-MS Chromatography
3.3. Optimization of Bio Fabrication Process
3.3.1. Temperature Optima
3.3.2. Time Course
3.3.3. Effect of pH
3.3.4. Plant Extract Volume
3.3.5. Silver Nitrate Concentration
3.4. Physiochemical Characteristics of VN-AgNPs
3.4.1. UV–Visible Spectrophotometric Analysis
3.4.2. FTIR (Fourier Transform Infrared)
3.4.3. X-Ray Diffraction (XRD)
3.4.4. SEM-EDX
3.4.5. Zeta Potential and DLS
3.5. Antibacterial and Cytotoxicity Analysis
3.6. Hemolytic Activity
4. Conclusions
Supplementary Materials
Author Contributions
Funding
Data Availability Statement
Acknowledgments
Conflicts of Interest
References
- Khan, F.; Shariq, M.; Asif, M.; Siddiqui, M.A.; Malan, P.; Ahmad, F. Green Nanotechnology: Plant-Mediated Nanoparticle Synthesis and Application. Nanomaterials 2022, 12, 673. [Google Scholar] [CrossRef] [PubMed]
- Noah, N.M.; Ndangili, P.M. Green Synthesis of Nanomaterials from Sustainable Materials for Biosensors and Drug Delivery. Sens. Int. 2022, 3, 100166. [Google Scholar] [CrossRef]
- Sharma, N.K.; Vishwakarma, J.; Rai, S.; Alomar, T.S.; AlMasoud, N.; Bhattarai, A. Green Route Synthesis and Characterization Techniques of Silver Nanoparticles and Their Biological Adeptness. ACS Omega 2022, 7, 27004–27020. [Google Scholar] [CrossRef] [PubMed]
- Sivapalan, S.; Dharmalingam, S.; Ashokkumar, V.; Venkatesan, V.; Angappan, M. Evaluation of the Anti-Inflammatory and Antioxidant Properties and Isolation and Characterization of a New Bioactive Compound, 3,4,9-Trimethyl-7-Propyldecanoic Acid from Vitex negundo. J. Ethnopharmacol. 2024, 319, 117314. [Google Scholar] [CrossRef]
- Meena, A.K.; Perumal, A.; Kumar, N.; Singh, R.; Ilavarasan, R.; Srikanth, N.; Dhiman, K.S. Studies on Physicochemical, Phytochemicals, Chromatographic Profiling & Estimation and in-Silico Study of Negundoside in Roots & Small Branches of Vitex negundo Plant. Phytomedicine Plus 2022, 2, 100205. [Google Scholar] [CrossRef]
- Hano, C.; Abbasi, B.H. Plant-Based Green Synthesis of Nanoparticles: Production, Characterization and Applications. Biomolecules 2021, 12, 31. [Google Scholar] [CrossRef]
- Arland, S.E.; Kumar, J. Green and chemical syntheses of silver nanoparticles: Comparative and comprehensive study on characterization, therapeutic potential, and cytotoxicity. Eur. J. Med. Chem. Rep. 2024, 11, 100168. [Google Scholar]
- Nasrullah, M.; Gul, F.Z.; Hanif, S.; Mannan, A.; Naz, S.; Ali, J.S.; Zia, M. Green and chemical syntheses of CdO NPs: A comparative study for yield attributes, biological characteristics, and toxicity concerns. ACS Omega 2020, 5, 5739–5747. [Google Scholar] [CrossRef]
- Llompart, M.; Garcia-Jares, C.; Celeiro, M.; Dagnac, T. Extraction | Microwave-Assisted Extraction. In Encyclopedia of Analytical Science, 3rd ed.; Worsfold, P., Poole, C., Townshend, A., Miró, M., Eds.; Academic Press: Oxford, UK, 2019; pp. 67–77. [Google Scholar] [CrossRef]
- Bruna, T.; Maldonado-Bravo, F.; Jara, P.; Caro, N. Silver Nanoparticles and Their Antibacterial Applications. Int. J. Mol. Sci. 2021, 22, 7202. [Google Scholar] [CrossRef]
- Dakal, T.C.; Kumar, A.; Majumdar, R.S.; Yadav, V. Mechanistic Basis of Antimicrobial Actions of Silver Nanoparticles. Front. Microbiol. 2016, 7, 1831. [Google Scholar] [CrossRef]
- Santhi, K.; Sengottuvel, R. Qualitative and Quantitative Phytochemical Analysis of Moringa concanensis Nimmo. Int. J. Curr. Microbiol. Appl. Sci. 2016, 5, 633–640. [Google Scholar] [CrossRef]
- Sivakumar, T. In vitro antioxidant, total phenolic, total flavonoid content and biosynthesis of silver nanoparticles using Cassia auriculata leaves extracts. Int. J. Botany. Stud. 2021, 6, 476–480. [Google Scholar]
- Silvestrini, A.; Meucci, E.; Ricerca, B.M.; Mancini, A. Total Antioxidant Capacity: Biochemical Aspects and Clinical Significance. Int. J. Mol. Sci. 2023, 24, 10978. [Google Scholar] [CrossRef] [PubMed]
- Ralte, L.; Khiangte, L.; Thangjam, N.M.; Kumar, A.; Singh, Y.T. GC–MS and Molecular Docking Analyses of Phytochemicals from the Underutilized Plant, Parkia timoriana Revealed Candidate Anti-Cancerous and Anti-Inflammatory Agents. Sci. Rep. 2022, 12, 3395. [Google Scholar] [CrossRef]
- Karimi, S.; Azizi, F.; Nayeb-Aghaee, M.; Mahmoodnia, L. The Antimicrobial Activity of Probiotic Bacteria Escherichia Coli Isolated from Different Natural Sources against Hemorrhagic E. Coli O157:H7. Electron. Physician 2018, 10, 6548–6553. [Google Scholar] [CrossRef]
- Aziz, S.B.; Abdullah, O.G.; Saber, D.R.; Rasheed, M.A.; Ahmed, H.M. Investigation of metallic silver nanoparticles through UV-Vis and optical micrograph techniques. Int. J. Electrochem. Sci. 2017, 12, 363–373. [Google Scholar] [CrossRef]
- Mughal, T.A.; Ali, S.; Mumtaz, S.; Summer, M.; Saleem, M.Z.; Hassan, A.; Hameed, M.U. Evaluating the biological (antidiabetic) potential of TEM, FTIR, XRD, and UV-spectra observed berberis lyceum conjugated silver nanoparticles. Microsc. Res. Tech. 2024, 87, 1286–1305. [Google Scholar] [CrossRef]
- Mehta, B.K.; Chhajlani, M.; Shrivastava, B.D. Green synthesis of silver nanoparticles and their characterization by XRD. J. Phys. Conf. Ser. 2017, 836, 012050. [Google Scholar] [CrossRef]
- Singh, V.; Shrivastava, A.; Wahi, N. Biosynthesis of silver nanoparticles by plants crude extracts and their characterization using UV, XRD, TEM and EDX. Afr. J. Biotechnol. 2015, 14, 2554–2567. [Google Scholar]
- Gontijo, L.A.; Raphael, E.; Ferrari, D.P.; Ferrari, J.L.; Lyon, J.P.; Schiavon, M.A. pH effect on the synthesis of different size silver nanoparticles evaluated by DLS and their size-dependent antimicrobial activity. Matéria 2020, 25, e-12845. [Google Scholar] [CrossRef]
- Mandal, M.K.; Domb, A.J. Antimicrobial Activities of Natural Bioactive Polyphenols. Pharmaceutics 2024, 16, 718. [Google Scholar] [CrossRef] [PubMed]
- Blomstrand, E.; Posch, E.; Stepulane, A.; Rajasekharan, A.; Andersson, M. Antibacterial and Hemolytic Activity of Antimicrobial Hydrogels Utilizing Immobilized Antimicrobial Peptides. Int. J. Mol. Sci. 2024, 25, 4200. [Google Scholar] [CrossRef] [PubMed]
- Gligor, O.; Clichici, S.; Moldovan, R.; Muntean, D.; Vlase, A.-M.; Nadăș, G.C.; Matei, I.A.; Filip, G.A.; Vlase, L.; Crișan, G. The Effect of Extraction Methods on Phytochemicals and Biological Activities of Green Coffee Beans Extracts. Plants 2023, 12, 712. [Google Scholar] [CrossRef] [PubMed]
- Shaikh, J.R.; Patil, M. Qualitative tests for preliminary phytochemical screening: An overview. Int. J. Chem. Stud. 2020, 8, 603–608. [Google Scholar] [CrossRef]
- Manso, T.; Lores, M.; de Miguel, T. Antimicrobial Activity of Polyphenols and Natural Polyphenolic Extracts on Clinical Isolates. Antibiotics 2021, 11, 46. [Google Scholar] [CrossRef]
- Satchanska, G. Antibacterial Activity of Plant Polyphenols. In Secondary Metabolites–Trends and Reviews; IntechOpen: London, UK, 2022. [Google Scholar] [CrossRef]
- Asbbane, A.; Ibourki, M.; Hallouch, O.; Oubannin, S.; El Boukhari, A.; Bouyahya, A.; Goh, K.W.; Al Abdulmonem, W.; Ait Aabd, N.; Guillaume, D.; et al. A comparative evaluation of the physico-and bio-chemical characteristics and antioxidant activities of six Argan (Argania spinosa (L.) Skeels) varieties. J. Agric. Food Res. 2025, 19, 101582. [Google Scholar] [CrossRef]
- Sharma, E.; Gaur, N.; Singh, S.; Mathur, K.; Kumar, K.; Wahi, N.; Garg, G. Extraction optimization of bioactive compounds from Vitex negundo through RSM: GC–MS, FTIR, in silico analysis, and antibacterial activity. J. Plant Biochem. Biotechnol. 2025. [Google Scholar] [CrossRef]
- Wang, Y.; Li, X.; Jiang, Q.; Sun, H.; Jiang, J.; Chen, S.; Guan, Z.; Fang, W.; Chen, F. GC-MS analysis of the volatile constituents in the leaves of 14 Compositae plants. Molecules 2018, 23, 166. [Google Scholar] [CrossRef]
- Kumar, A.; Kaur, S.; Dhiman, S.; Pal Singh, P.; Thakur, S.; Sharma, U.; Kumar, S.; Kaur, S. 1,2-Benzenedicarboxylic Acid, Bis (2-Methyl Propyl) Ester Isolated from Onosma Bracteata Wall. Inhibits MG-63 Cells Proliferation via Akt-P53-Cyclin Pathway. Res. Sq. 2021. [Google Scholar] [CrossRef]
- Zhang, H.; Jiang, Z.; Shen, C.; Zou, H.; Zhang, Z.; Wang, K.; Bai, R.; Kang, Y.; Ye, X.-Y.; Xie, T. 5-Hydroxymethylfurfural Alleviates Inflammatory Lung Injury by Inhibiting Endoplasmic Reticulum Stress and NLRP3 Inflammasome Activation. Front. Cell Dev. Biol. 2021, 9, 782427. [Google Scholar] [CrossRef]
- Onoja, J. Effects of 5-Hydroxymethylfurfural Isolated from Cola Hispida on Oral Adenosquamous Carcinoma and MDR Staphylococcus Aureus. J. Med. Plant Herb. Ther. Res. 2021, 8, 1–7. [Google Scholar]
- Ochieng Nyalo, P.; Isanda Omwenga, G.; Piero Ngugi, M. GC-MS Analysis, Antibacterial and Antioxidant Potential of Ethyl Acetate Leaf Extract of Senna Singueana (Delile) Grown in Kenya. Evid. Based Complement. Altern. Med. 2022, 2022, 5436476. [Google Scholar] [CrossRef] [PubMed]
- Hassane, A.M.A.; Hussien, S.M.; Abouelela, M.E.; Taha, T.M.; Awad, M.F.; Mohamed, H.; Hassan, M.M.; Hassan, M.H.A.; Abo-Dahab, N.F.; El-Shanawany, A.-R.A. In Vitro and In Silico Antioxidant Efficiency of Bio-Potent Secondary Metabolites From Different Taxa of Black Seed-Producing Plants and Their Derived Mycoendophytes. Front. Bioeng. Biotechnol. 2022, 10, 930161. [Google Scholar] [CrossRef] [PubMed]
- Lee, H.Y.; Back, K. The Antioxidant Cyclic 3-Hydroxymelatonin Promotes the Growth and Flowering of Arabidopsis Thaliana. Antioxidants 2022, 11, 1157. [Google Scholar] [CrossRef]
- Lomelí-Rosales, D.A.; Zamudio-Ojeda, A.; Reyes-Maldonado, O.K.; López-Reyes, M.E.; Basulto-Padilla, G.C.; Lopez-Naranjo, E.J.; Zuñiga-Mayo, V.M.; Velázquez-Juárez, G. Green Synthesis of Gold and Silver Nanoparticles Using Leaf Extract of Capsicum Chinense Plant. Molecules 2022, 27, 1692. [Google Scholar] [CrossRef]
- Malik, M.; Iqbal, M.A.; Malik, M.; Raza, M.A.; Shahid, W.; Choi, J.R.; Pham, P.V. Biosynthesis and Characterizations of Silver Nanoparticles from Annona Squamosa Leaf and Fruit Extracts for Size-Dependent Biomedical Applications. Nanomaterials 2022, 12, 616. [Google Scholar] [CrossRef]
- Ajaykumar, A.P.; Mathew, A.; Chandni, A.P.; Varma, S.R.; Jayaraj, K.N.; Sabira, O.; Rasheed, V.A.; Binitha, V.S.; Swaminathan, T.R.; Basheer, V.S.; et al. Green Synthesis of Silver Nanoparticles Using the Leaf Extract of the Medicinal Plant, Uvaria Narum and Its Antibacterial, Antiangiogenic, Anticancer and Catalytic Properties. Antibiotics 2023, 12, 564. [Google Scholar] [CrossRef]
- Giri, A.K.; Jena, B.; Biswal, B.; Pradhan, A.K.; Arakha, M.; Acharya, S.; Acharya, L. Green Synthesis and Characterization of Silver Nanoparticles Using Eugenia Roxburghii DC. Extr. Act. Against Biofilm-Prod. Bacteria. Sci. Rep. 2022, 12, 8383. [Google Scholar] [CrossRef]
- Sundar, M.; Rajagopal, G.; Nivetha, A.; Prabu Kumar, S.; Muthukumar, S. Phyto-Mediated Green Synthesis of Silver Nanoparticles Using an Aqueous Leaf Extract of Momordica Cymbalaria: Antioxidant, Cytotoxic, Antibacterial, and Photocatalytic Properties. Separations 2024, 11, 61. [Google Scholar] [CrossRef]
- Liu, H.; Zhang, H.; Wang, J.; Wei, J. Effect of Temperature on the Size of Biosynthesized Silver Nanoparticle: Deep Insight into Microscopic Kinetics Analysis. Arab. J. Chem. 2020, 13, 1011–1019. [Google Scholar] [CrossRef]
- Ansari, M.; Ahmed, S.; Abbasi, A.; Khan, M.T.; Subhan, M.; Bukhari, N.A.; Hatamleh, A.A.; Abdelsalam, N.R. Plant mediated fabrication of silver nanoparticles, process optimization, and impact on tomato plant. Sci. Rep. 2023, 13, 18048. [Google Scholar] [CrossRef] [PubMed]
- Muhammad, R.; Mutreja, V.; Sareen, S.; Ahmad, B.; Faheem, M.; Zahid, N.; Jabbour, G.; Park, J. Exceptional antibacterial and cytotoxic potency of monodisperse greener AgNPs prepared under optimized pH and temperature. Sci. Rep. 2021, 11, 2866. [Google Scholar]
- Molleman, B.; Hiemstra, T. Time, pH, and size dependency of silver nanoparticle dissolution: The road to equilibrium. Environ. Sci. Nano 2017, 4, 1314–1327. [Google Scholar] [CrossRef]
- Fernando, I.; Zhou, Y. Impact of pH on the stability, dissolution and aggregation kinetics of silver nanoparticles. Chemosphere 2019, 216, 297–305. [Google Scholar] [CrossRef]
- Bergal, A.; Matar, G.H.; Andaç, M. Olive and Green Tea Leaf Extracts Mediated Green Synthesis of Silver Nanoparticles (AgNPs): Comparison Investigation on Characterizations and Antibacterial Activity. BioNanoScience 2022, 12, 307–321. [Google Scholar] [CrossRef]
- Ghoshal, G.; Singh, M. Characterization of silver nano-particles synthesized using fenugreek leave extract and its antibacterial activity. Mater. Sci. Energy Technol. 2022, 5, 22–29. [Google Scholar] [CrossRef]
- Restrepo, C.V.; Villa, C.C. Synthesis of silver nanoparticles, influence of capping agents, and dependence on size and shape: A review. Environ. Nanotechnol. Monit. Manag. 2021, 15, 100428. [Google Scholar] [CrossRef]
- Singh, S.; Bharti, A.; Meena, V.K. Green Synthesis of Multi-Shaped Silver Nanoparticles: Optical, Morphological and Antibacterial Properties. J. Mater. Sci. Mater. Electron. 2015, 26, 3638–3648. [Google Scholar] [CrossRef]
- Miranda, A.; Akpobolokemi, T.; Chung, E.; Ren, G.; Raimi-Abraham, B.T. pH alteration in plant-mediated green synthesis and its resultant impact on antimicrobial properties of silver nanoparticles (AgNPs). Antibiotics 2022, 11, 1592. [Google Scholar] [CrossRef]
- Dash, B.; Mishra, R.K.; Panda, S.K. In-vitro antioxidant activity, pharmacognostical evaluation, HPTLC and FTIR fingerprinting of Phyllanthus acidus L. stem bark extract. Biomed. Pharmacol. J. 2023, 16, 1575–1583. [Google Scholar]
- Ogbe, R.J.; Ojighenvo, A.J.; Nwajiaku, L.O.; Audu, O.C.; Ibeji, C.U. FTIR analysis of the phytochemical components of Urtica dioica L. (Urticaceae) whole plant. J. Pharmacogn. Phytother. 2021, 13, 30–35. [Google Scholar]
- Ali, M.H.; Azad, M.A.K.; Khan, K.A.; Rahman, M.O.; Chakma, U.; Kumer, A. Analysis of Crystallographic Structures and Properties of Silver Nanoparticles Synthesized Using PKL Extract and Nanoscale Characterization Techniques. ACS Omega 2023, 8, 28133–28142. [Google Scholar] [CrossRef] [PubMed]
- Zulfiqar, Z.; Khan, R.R.; Summer, M.; Saeed, Z.; Pervaiz, M.; Rasheed, S.; Shehzad, B.; Kabir, F.; Ishaq, S. Plant-mediated green synthesis of silver nanoparticles: Synthesis, characterization, biological applications, and toxicological considerations: A review. Biocatal. Agric. Biotechnol. 2024, 19, 103121. [Google Scholar] [CrossRef]
- Alghoraibi, I.; Soukkarieh, C.; Zein, R.; Alahmad, A.; Walter, J.G.; Daghestani, M. Aqueous extract of Eucalyptus camaldulensis leaves as reducing and capping agent in biosynthesis of silver nanoparticles. Inorg. Nano-Met. Chem. 2020, 50, 895–902. [Google Scholar] [CrossRef]
- Ahmad, S.; Ahmad, S.; Xu, Q.; Khan, I.; Cao, X.; Yang, R.; Yan, H. Green Synthesis of Gold and Silver Nanoparticles Using Crude Extract of Aconitum Violaceum and Evaluation of Their Antibacterial, Antioxidant and Photocatalytic Activities. Front. Bioeng. Biotechnol. 2024, 11, 1320739. [Google Scholar] [CrossRef]
- Mazzonello, A.; Valdramidis, V.V.; Farrugia, C.; Grima, J.N.; Gatt, R. Synthesis and characterization of silver nanoparticles. Int. J. Morden Eng. Res. 2017, 7, 41–47. [Google Scholar]
- Fareed, N.; Nisa, S.; Bibi, Y.; Fareed, A.; Ahmed, W.; Sabir, M.; Alam, S.; Sajjad, A.; Kumar, S.; Hussain, M.; et al. Green Synthesized Silver Nanoparticles Using Carrot Extract Exhibited Strong Antibacterial Activity against Multidrug Resistant Bacteria. J. King Saud. Univ.—Sci. 2023, 35, 102477. [Google Scholar] [CrossRef]
- Hamad, A.; Khashan, K.S.; Hadi, A. Silver nanoparticles and silver ions as potential antibacterial agents. J. Inorg. Organomet. Polym. Mater. 2020, 30, 4811–4828. [Google Scholar] [CrossRef]
- Urnukhsaikhan, E.; Bold, B.-E.; Gunbileg, A.; Sukhbaatar, N.; Mishig-Ochir, T. Antibacterial Activity and Characteristics of Silver Nanoparticles Biosynthesized from Carduus Crispus. Sci. Rep. 2021, 11, 21047. [Google Scholar] [CrossRef]
- Nelsonjoseph, L.; Vishnupriya, B.; Amsaveni, R.; Bharathi, D.; Thangabalu, S.; Rehna, P. Synthesis and characterization of silver nanoparticles using Acremonium borodinense and their anti-bacterial and hemolytic activity. Biocatal. Agric. Biotechnol. 2022, 39, 102222. [Google Scholar] [CrossRef]
- Bhattacharjee, S. DLS and zeta potential–what they are and what they are not? J. Control. Release 2016, 235, 337–351. [Google Scholar] [CrossRef] [PubMed]
- Kumar, K.V.; Varadaraju, K.R.; Shivaramu, P.D.; Kumar, C.H.; Prakruthi, H.R.; Shekara, B.C.; Shreevatsa, B.; Wani, T.A.; Prakasha, K.C.; Kollur, S.P.; et al. Bactericidal, anti-hemolytic, and anticancerous activities of phytofabricated silver nanoparticles of glycine max seeds. Front. Chem. 2024, 12, 1427797. [Google Scholar] [CrossRef] [PubMed]
- Phuyal, N.; Jha, P.K.; Raturi, P.P.; Rajbhandary, S. Total phenolic, flavonoid contents, and antioxidant activities of fruit, seed, and bark extracts of Zanthoxylum armatum DC. Sci. World J. 2020, 2020, 8780704. [Google Scholar] [CrossRef] [PubMed]
- Ezealigo, U.S.; Joshua, P.E.; Ononiwu, C.P.; Agbo, M.O.; Asomadu, R.O.; Ogugua, V.N. Total phenolic and flavonoid content and in vitro antioxidant activity of methanol extract and solvent fractions of Desmodium ramosissimum G. Don. Med. Sci. Forum 2021, 2, 15. [Google Scholar]
- Bala, A.; Rani, G. A review on phytosynthesis, affecting factors and characterization techniques of silver nanoparticles designed by green approach. Int. Nano Lett. 2020, 10, 159–176. [Google Scholar] [CrossRef]

Disclaimer/Publisher’s Note: The statements, opinions and data contained in all publications are solely those of the individual author(s) and contributor(s) and not of MDPI and/or the editor(s). MDPI and/or the editor(s) disclaim responsibility for any injury to people or property resulting from any ideas, methods, instructions or products referred to in the content. |
© 2025 by the authors. Licensee MDPI, Basel, Switzerland. This article is an open access article distributed under the terms and conditions of the Creative Commons Attribution (CC BY) license (https://creativecommons.org/licenses/by/4.0/).
Share and Cite
Yadav, M.; Gaur, N.; Wahi, N.; Singh, S.; Kumar, K.; Amoozegar, A.; Sharma, E. Phytochemical-Assisted Fabrication of Biogenic Silver Nanoparticles from Vitex negundo: Structural Features, Antibacterial Activity, and Cytotoxicity Evaluation. Colloids Interfaces 2025, 9, 55. https://doi.org/10.3390/colloids9050055
Yadav M, Gaur N, Wahi N, Singh S, Kumar K, Amoozegar A, Sharma E. Phytochemical-Assisted Fabrication of Biogenic Silver Nanoparticles from Vitex negundo: Structural Features, Antibacterial Activity, and Cytotoxicity Evaluation. Colloids and Interfaces. 2025; 9(5):55. https://doi.org/10.3390/colloids9050055
Chicago/Turabian StyleYadav, Mohit, Nisha Gaur, Nitin Wahi, Sandeep Singh, Krishan Kumar, Azadeh Amoozegar, and Eti Sharma. 2025. "Phytochemical-Assisted Fabrication of Biogenic Silver Nanoparticles from Vitex negundo: Structural Features, Antibacterial Activity, and Cytotoxicity Evaluation" Colloids and Interfaces 9, no. 5: 55. https://doi.org/10.3390/colloids9050055
APA StyleYadav, M., Gaur, N., Wahi, N., Singh, S., Kumar, K., Amoozegar, A., & Sharma, E. (2025). Phytochemical-Assisted Fabrication of Biogenic Silver Nanoparticles from Vitex negundo: Structural Features, Antibacterial Activity, and Cytotoxicity Evaluation. Colloids and Interfaces, 9(5), 55. https://doi.org/10.3390/colloids9050055

